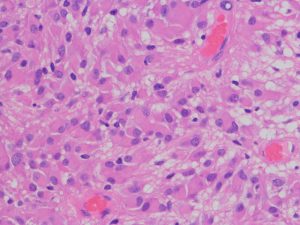

上衣下巨細胞性星細胞腫,結節性硬化症,SEGA
上衣下巨細胞性星細胞腫
subepedymal giant cell astrocytoma SEGA (セガ)
(結節性硬化症 tuberous sclerosis は下の方に詳しく書いてあります)
- 小児や青年の側脳室の壁にできる腫瘍です
- 結節性硬化症の患者さんには,多発性の腫瘍ができることがあります
- 結節性硬化症の主症状は,治療が難しいてんかんですが,10%くらいの子どもでSEGAが問題となります
- 結節性硬化症と診断されたら定期的に脳のMRIをするので早期に発見されます
- ほとんどが小児期(20歳未満)に発症します
- 結節性硬化症がない人にできることもあり,孤発性SEGAといいます
- 孤発性の場合は腫瘍は一つだけです
- グレード1の良性の腫瘍です
- 無症候で発見された場合には経過を見ても症状がでないことがあります
- 通常は,何年もかけてゆっくり増大します
- ですから,10年以上にわたって慎重に経過を見なければなりません
- 結節性硬化症の場合は,てんかんで発症して,MRI検査をすると脳室内に小さな結節がたくさんあるのが偶然見つかります
- この時,発見されるのは上衣下結節 SENといって,上衣下巨細胞性星細胞腫 SEGA ではありません
- 小さな多発性上衣下結節は症状を出していません
- 症状を出すのは,SEGAとなって,大きくなって,モンロー孔という髄液の通り道がふさがって水頭症になる時です
- これを閉塞性水頭症といいますが,頭痛や嘔吐を生じます
- 頭痛や嘔吐や麻痺まで出ても,てんかん発作と間違われて見逃され,意識障害になって初めてSEGAと診断された子どもを見たことがあります
- 結節性硬化症の場合は,CTでみると,たくさんの石灰化(白い点)がみられます
- 結節性硬化症では,MRIでみると,脳室の壁にコブがたくさんあるようにがボコボコしています
- 腫瘍が明らかに増大するとき,閉塞性水頭症が進行する時だけ治療を考えます
- 急性水頭症や腫瘍内出血で,頭痛から意識障害へと急性発症することが稀にあります
- 標準治療は手術摘出です,手術で全部とれれば治ります
- でも,難しい手術となりますし,取り残せば再燃(再発)します
- 増大傾向を示すSEGAを手術するかどうか決めるタイミングの決定は難しく議論があります
- 外科的摘出の適応とならない時は薬物治療(化学療法)をします
- mTOR(エムトール)阻害剤という薬を使います
- シロリムスとエベロリムス(アフィニトール)という抗がん剤で腫瘍縮小効果があります
- アフィニトールは,日本でも2012年からSEGAに対して認可され使用されています
- 非常に長期の投与となるので薬剤費がとても高額なことが問題となっています
- 大きなSEGAでは,エベロリムスを手術前投与をするべきでしょう
- 手術や化学療法の適応とならず,小さなSEGAで増大して来るものには放射線外科治療も有効です
診断
- 結節性硬化症では,cortical tuberは半数ほどでみられ,側脳室壁にコブのような上衣下結節 subependymal nodules が多数認められます
- 上衣下結節がSEGAとなって増大する場合には,尾状核頭(モンロー孔周囲)に多いですが,まれに第3脳室壁,第4脳室壁,大脳基底核にも発生します
- SEGAは症状を出さないものがほとんどです
- 10mm以上の大きさになると,モンロー孔を閉塞して水頭症を生じて症候性となることがあります
- CTでは,散在性の多数の石灰化として捉えられます
- 腫瘍化したものの内部には大きな石灰化が認められます
- 腫瘍実質は灰白質と同密度あるいはやや低密度です
- MRIでは,T1 iso/low intense, T2 hetero/hyper intenseです
- CT/MRIで,subependymal nodulesが 造影剤で増強されないのにたいして,SEGAは強く増強されるので,結節性硬化症の小児においては一度は造影所見を確認しておくべきです
- 急速に増大するものでは腫瘍内出血を生じることがあります
結節性硬化症 TSに見られる多発性上衣下結節 subependymal nodules
32歳で初めて睡眠時てんかん発症した患者さんのものです。側脳室壁だけに無数の上衣下結節がありますが,治療の必要はありません。SEGAではありません。
症候性の大きなSEGA
水頭症で発症した10歳の男の子のSEGAです。左側脳室の前角という部位から発生しました。腫瘍は右の脳室にものう胞を形成して,両側のモンロー孔を塞いだために閉塞性水頭症になって,頭痛と嘔吐が出ました。腫瘍の前方には腫瘍内出血もあります。

経皮質法 transcortical approachで摘出した後のMRI画像です。手術中には腫瘍からの出血は多く,深い位置にあり脳質壁を損傷しないように全摘出するのは難しいものでした。その後10年以上たっていますが再発していません。
この例は結節性硬化症を伴わないものでした。
central neurocytomaとの鑑別
孤発性SAGAの場合は側脳室内に発生する中枢性神経細胞種 central neurocytomaとの鑑別が難しいことがありますが,SEGAが尾状核頭に発生するのに対して,central neurocytomaが透明中核に発生することが多いので,腫瘍の位置で見分けることができます。central neurocytomaは両惻脳室中央,SEGAは惻脳室前方片側という特徴です。両者ともに閉塞性水頭症を呈して発症するので,巨大な腫瘍となっていることが多いし,両者ともに腫瘍内出血を生じることがあるので,これらは鑑別点となりません。
急性発症するSEGAへの対処
- モンロー孔閉塞による急性水頭症で,頭痛と嘔吐,進行すると意識障害になり,緊急入院となることがあります
- 腫瘍内出血で急性発症することもあります
- 最近では結節性硬化症の患者さんは定期的なMRI検査を受けるので急性に発症することはほとんどありません
- 孤発性SEGAは,急性閉塞性水頭症で発症して発見されることがあります
- 腫瘍内出血で急激に腫瘍が増大してモンロー孔を閉塞して,急性水頭症で発症することがあります
- 開頭手術による腫瘍摘出は簡単ではないので,技術的に難しいと考えたら急性水頭症の改善を優先して行います
- 腫瘍摘出の成績は執刀医の技量によってかなり左右されるので,すぐに腫瘍を摘出した方がいいかどうかは搬入された施設の経験値も含めて考えます
- まず水頭症をコントロールするために,脳室外ドレナージ,内視鏡による透明中核穿孔 septostomy,シャント手術を行います
- その時点でアフィニトールで小さくしてから摘出した方がいいのか,手術だけで治るのか考えます
- 手術で摘出できれば治る腫瘍ですから,もちろん腫瘍摘出は積極的な選択肢として考えます
- 出血性腫瘍ですから内視鏡手術はリスクが大きいので,開頭顕微鏡手術の方がいいでしょう
- 開頭手術は,前頭葉から経皮質アプローチ transcortical approachを用います
手術アプローチ
- モンロー孔周囲に発生するので,小さなものであればanterior transcallosal approachで摘出できます
- しかし,それより前方の前角にある時には,脳梁膝部の損傷を避けるために,nevigationを用いるfrontal transcortical approachがよいでしょう
- 数cmに及ぶ腫瘍では,これも脳梁膝部の損傷を避けるためにfrontal transcortical approachを用います
- transcallsal approachよりも,frontal transcortical approachの方が腫瘍の全貌を術野内部に捉えやすいです
- 巨大な腫瘍では,腫瘍からの出血も多く止血に難渋することもあります
- SEGAは部分摘出するとまた再増大してしまう腫瘍です
- 内視鏡手術では大きなものの全摘出は無理ですから,2cm以内の小さなSEGAのみの適応となります
SEGAに対する化学療法 アフィニトール
- mTOR (manmalian target of rapamycin) inhibitorである,シロリムス sirolimus やエベロリムス everolimus という薬剤が有効です
- 2012年,アフィニトール(エベロリムス)が保険診療で認可されて以来,幼児期からSEGAの増大に対して使用されるようになりました
- 臨床第3相試験の結果では,エベロリムス使用した約半数に腫瘍縮小(50%減量)が認められたと報告されました
- 腫瘍縮小効果は3ヶ月以内くらいで判断できます
- 一時的な腫瘍増大抑制効果はありますが,残念ながら投与の中止とともに再増大を生じることが多いです
- 腫瘍が消失して治ってしまうということはないと考えた方がいいでしょう
- 大きなSEGAに対しては,シロリムスやエベロリムス術前投与により,腫瘍縮小効果が得られ腫瘍摘出が容易になったという報告が相次いでいます
- 巨大なSEGAでは手術前に使用されるべき薬剤です
- 3 – 5年間ほど継続治療されることがあります
- しかし,中断による腫瘍再増大があるので,どの時期にアフィニトール治療を中断するかは難しい判断です,2018年時点では結論が出ていません
アフィニトールを使うべきか
- 単にSEGAがあるからアフィニトールを使用するということはしません
- SEGAが消えて無くなってしまうからではないからです
- SEGAが大きくなるのを防ぐ,あるいは少しは小さくしたいという目的です
- 結節性硬化症 TSは,全身の様々な臓器に,いろいろな腫瘍や症状を呈する複雑な complex病気です
- 眼,腎臓,皮膚,心臓,てんかん,などの病変の抑制を目的としてもアフィニトールは使用されます
- SEGAだけではなくて,全身臓器の合併症にも有効である可能性をよくよく考えて使います
使用方法
エベロリムス 3mg/m2 1日1回 水に分散して経口投与します
- 一度投与を開始すると可能であれば数年間という長い期間にわたっての投与が必要です
- 投薬は小児科の血液腫瘍科からしていただいて,トラフ濃度(血中濃度)が 5-15ng/mLになるように投与量を調節します
- 有害事象は,最も多いのが口内炎で,まれに間質性肺炎などの感染症です
- 保険が利かないと,3mgで8,092.5円ですから,1年間の薬剤費(薬代だけ)が300万円前後になります
エベロリムス投与後の摘出
10歳の時に水頭症による頭痛と嘔吐で発症しました。結節性硬化症に合併したSEGAです。生検術,内視鏡手術,開頭術を受けて腫瘍を小さくして,その後にエベロリムスの投与を受けていました。これはエベロリムス投与後の画像です。この腫瘍にさらにエベロリムスの投与を続けるかという疑問があります。やめれば再燃することが多いからです。
結論として,これは完全摘出できるので摘出した方がいいです。なぜならそれでこの腫瘍は治癒するからです。右のFLAIR画像で見られるように発生部位となる尾状核のところでは一見,脳組織との境界が不明瞭にみえるのですが,腫瘍はある程度の硬さがあるので脳組織との区別をすることができて,完全摘出できるものです。
放射線治療
- 手術で摘出できない,かつアフィニトールでコントロール不能なSEGAには,残された唯一の治療手段です
- ガンマナイフなどの放射線外科治療で制御できたという報告は少ないながらあります
- ただし,腫瘍に隣接する脳弓や前交連に大きな被曝があると,脳弓機能低下が生じて,記憶認知機能低下が遅発性に進行する可能性を考えなければなりません
病理と予後
- TSC1/TSC2 mutation 遺伝子変異が原因です
- 多くの場合,結節性硬化症にみられるsubependymal noduleは大きくなりません
- まれに一部がSEGAとなって増大します
- ほとんどが25歳以下で発生しますから,成人になってから新たなSEGAができることはほとんどありません
- 病理像では,好酸性の胞体 glassy eosinophilic cytoplasm を有する不整形の巨細胞の存在が特徴です
- 核は,多型で複数核 pleomorohic binucleate to multinucleate,クロマチンは粗,核小体が明瞭で神経節細胞様の大型のものもみられます
- 腫瘍細胞にはGFAP, vimentine, S-100が陽性で,巨細胞はNF, NSEなどが陽性となることがあります
- 血管増殖像はなく,核分裂もなく,組織の異型性に反して臨床的には良性腫瘍の性格を呈します
- 予後は良好であるので,手術で神経脱落症状を出さないように最大限の努力をします
結節性硬化症 tuberous sclerosis complex TSC
- 日本には10,000人に1人,1万人以上の患者さんがいると推定されます
- 古くはプリングル病といわれた神経皮膚症候群(母斑症)の一種です
- 常染色体性優性遺伝性疾患です
- 小児期から難治性てんかん,自閉症,精神発達遅滞,認知機能障害,行動異常,上衣下巨細胞性星細胞腫などを合併します
- 10 – 20%ほどの患者さんにSEGAが発生します
- 臨床診断は,複数臓器での特徴的な過誤腫 hamartomaの発生で確定されます
- 脳以外にも,心臓,皮膚(顔面血管線維腫 facial angiofibroma),腎臓(腎血管筋脂肪腫 angiomyolipoma),肺(肺リンパ管平滑筋腫症 lymphangioleiomyomatosis) をはじめ,ほとんどすべての臓器に腫瘍(非悪性過誤種 nonmalignant hamartoma) が発生する可能性があります
- 皮膚白斑や爪の線維腫があることも診断基準の一つに含まれます
- 第9染色体9q34のTSC1遺伝子 (hamartin),第16染色体16p13.3のTSC2遺伝子 (tubelin) の変異によって発生します
- TSC1/TSC2 protein dimer complexは,mTOR (manmalian target of rapamycin) の抑制因子です
- 遺伝子診断は臨床診断の補助として用います
- ほとんどの罹患者で1歳までに発作を発症して,infantile spasm, epileptic spasms, refractory complex epilepsy, Lennox-Gstaut syndromeなど様々なてんかん発作を生じます
- 薬物治療で,てんかんのコントロールが可能ですが,難しい治療となります
- 点頭てんかん(ウエスト症候群)には,ビガバトリン(サブリル)が有効ですが,視野障害の副作用があるので限られた施設でしか用いられません
- てんかん発作のコントロールが不良な例で,認知機能の悪化を招くことが多いです
- 腫瘍の治療は,各臓器の病変に応じて選択されます
- 外科的腫瘍摘出が中心ですが,mTOR inhibitorであるsirolimusとeverolimusは,TSCに合併するsubependymal giant cell astrocytoma, angiofibroma, angiomyoliomaに対して腫瘍縮小効果があり,肺機能も改善するとの報告が多いです
- シロリムスとエベロリムスはもともと免疫抑制剤です
- シロリムスはラパマイシンとも呼ばれ,ラパミューンは商品名です
- エベロリムスはシロリムスの誘導体であり,商品名はサーティカン,アフィニトールです
- エベロリムスは,治療抵抗性のてんかん部分発作を軽減する作用も有しています
乳児期にてんかん発作で発症した結節性硬化症
黄色の矢印で示すように脳室の壁に多数の小結節 (subependymal nodule SEN) があります。これらの結節はCTでは石灰化としてはっきり描出されますからCTの方が見やすいといえます。赤の矢印で示したのは,左前角 (caudothalamic groove) の腫瘍はSEGAですが,8年間観察してもほとんど増大しませんでした。でも今後に大きくなる可能性は否定できないものですから,これから何年も経過観察が必要です。
黄色の矢印は右の三角部のSEGAです。右の写真で大脳の皮質下白質が白くにじんで見える大脳皮質結節(cortical tubers) のも結節性硬化症の特徴です。このような病変がてんかん発作を生じます。
文献情報
シロリムスでは結節性硬化症のてんかん発作を抑制できない
Overwater IE: Sirolimus for epilepsy in children with tuberous sclerosis complex: A randomized controlled trial. Neurology. 2016
23人の子供たちで無作為臨床試験が行われました。目標の症例に達しなかったので有意差ははっきりしませんでしtが,シロリムス投与は発作頻度を有意に低下させないと結論されました。
エベロリムス(アフィニトール)の長期投与の効果
Franz DN, et al.: Everolimus for subependymal giant cell astrocytoma in patients with tuberous sclerosis complex: 2-year open-label extension of the randomised EXIST-1 study. Lancet Oncol 15:1513-1520, 2014
下の論文の続きの報告です。投与期間中央値29ヶ月の後,経過観察期間中央値28ヶ月で,49%の患者さんに腫瘍縮小(量で半分以下)が認められました。口内炎 43% と口唇潰瘍 30% が主たる有害事象でした。頻度は低いのですが重症感染症が発生しています。
エベロリムス(アフィニトール)の効果
Franz DN, et al.: Efficacy and safety of everolimus for subependymal giant cell astrocytomas associated with tuberous sclerosis complex (EXIST-1): a multicentre, randomised, placebo-controlled phase 3 trial. Lancet 381: 125-132, 2013
117人の患者さんが登録された無作為第3相試験です。1cm以上で増大傾向を示すSEGAあるいは症候性水頭症を有する症例に使用されました。腫瘍縮小 (50% reduction in volume) は,エベロリムス群(78例)35%に対してプラセボ群(39例)では0%でした。有害事象は口内炎と口腔内潰瘍,上気道感染症でほとんどがgrade 1/2の軽度のものでした。有害事象のために投薬が中止となった患者さんはいませんでした。長期投与が可能な薬剤だと判断されています。
エベロリムス(アフィニトール)の長期投与
Krueger DA, et al.: Everolimus long-term safety and efficacy in subependymal giant cell astrocytoma. Neurology 80: 574-580, 2013
結節性硬化症に発生したSEGAを有する28人の患者さんがアフィニトールで治療されました。経口投与で投与量中央値は5.3 mg/m2/dayでした。25人の患者さんでは中断することなく投与が継続中であり,その期間中央値は34ヶ月です。7割程度の患者さんで30%くらい腫瘍体積が減量しました。有害事象のために薬剤投与中断となった例はありませんでした。最も多いのが上気道感染 (85.7%),口内炎 (46.4%),中耳炎 (35.7%)でした。titrated to trough serum levels of 5-15 ng/mL, was effective in reducing tumor size in patients with SEGA secondary to TSCと書かれています。
エベロリムス(アフィニトール)の幼児てんかん発作に対する効果
Kotulska K, et al.: Long-term effect of everolimus on epilepsy and growth in children under 3 years of age treated for subependymal giant cell astrocytoma associated with tuberous sclerosis complex. Eur J Paediatr Neurol 17: 479-485, 2013
3歳未満の8人の幼児にアフィニトールが投与されました。5人の幼児に治療抵抗性のてんかんがありました。平均追跡期間は35か月でした。6人の子どもでSEGAが縮小しました。1人で薬剤抵抗性のてんかん発作が消失して,2人で発作回数が半分以下となりました。この報告時点では全員がアフィニトールの継続投与を受けていますが,いつまで投与を続けるべきかについては記載されていないので不明です。
SEGAの病理像
基本的には,大きくて太った細胞 large plump cells で構成されます。gemistocytic astrocytesにています。
polygonal cells, ganglionic-like cells with a clear nucleoli, and plump large tumor cells resembling gemistocytic astrocytes
multinucleated giant cells
perivascular pseudorosettes, sweeping fascicles
文献
- Dabora SL, et al.: Multicenter phase 2 trial of sirolimus for tuberous sclerosis: kidney angiomyolipomas and other tumors regress and VEGF- D levels decrease. PLoS One. 2011;6(9):e23379
- Franz DN, et al.: Efficacy and safety of everolimus for subependymal giant cell astrocytomas associated with tuberous sclerosis complex (EXIST-1): a multicentre, randomised, placebo-controlled phase 3 trial. Lancet 381: 125-132, 2013
- Franz DN: Everolimus in the treatment of subependymal giant cell astrocytomas, angiomyolipomas, and pulmonary and skin lesions associated with tuberous sclerosis complex. Biologics 7: 211-221, 2013
- Franz DN, et al.: Everolimus for subependymal giant cell astrocytoma in patients with tuberous sclerosis complex: 2-year open-label extension of the randomised EXIST-1 study. Lancet Oncol 15:1513-1520, 2014
- Geoerger B, et al.: Everolimus for astrocytomas in tuberous sclerosis complex. Lancet 381: 95-96, 2013
- Kohrman MH, Emerging treatments in the management of tuberous sclerosis complex. Pediatr Neurol 46:267-275, 2012
- Kotulska K, et al.: Long-term effect of everolimus on epilepsy and growth in children under 3 years of age treated for subependymal giant cell astrocytoma associated with tuberous sclerosis complex. Eur J Paediatr Neurol 17: 479-485, 2013
- Krueger DA, et al.: Current management of tuberous sclerosis complex. Paediatr Drugs 10:299-313, 2008
- Krueger DA, et al.: Everolimus long-term safety and efficacy in subependymal giant cell astrocytoma. Neurology 80: 574-580, 2013
- Perek-Polnik M, et al.: Effective everolimus treatment of inoperable, life-threatening subependymal giant cell astrocytoma and intractable epilepsy in a patient with tuberous sclerosis complex. Eur J Paediatr Neurol 16:83-85, 2012
- Roach ES, Gomez MR, Northrup H: Tuberous sclerosis complex consensus conference: revised clinical diagnostic criteria. J Child Neurol 13:624-628, 1998
- Staehler M, et al.: Nephron-sparing resection of angiomyolipoma after sirolimus pretreatment in patients with tuberous sclerosis. Int Urol Nephrol 44:1657-1661, 2012